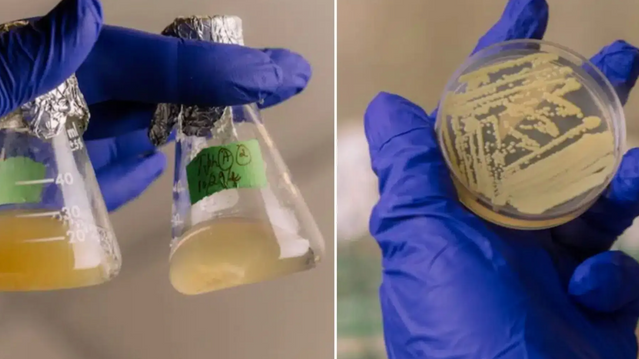
Bakterier «spiller døde» i Nasas renrom – kan få haik til Mars

Universet

Nå kan du se et lysende solsystem midt i Oslo

Fant mystiske mønstre – skyldes de atombomber og UFO-er?

De vil plassere 4000 speil i verdensrommet
Bakterier «spiller døde» i Nasas renrom – kan få haik til Mars
.jpg)
Edderkoppene som spiser stjerner – og forskerne som fanger dem

Europa skal lande på månen for første gang i 2028

Satellitter og søppel truer ozonlaget og sikkerheten i verdensrommet

IBM og Nasa lager digital tvilling av solen

Nå står planetene på linje: – Spektakulær himmel!

Nasa planlegger atomreaktor på månen, ifølge Politico

Helnorsk forskningsrakett skal skytes opp fra Andøya

Musk tror på Mars-reise allerede i 2026 – men ett problem gjenstår

Hvor kommer den mystiske strålingen fra?

Trump vil bruke milliarder på å få mennesker til Mars – men kutter i forskning
